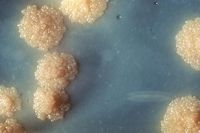
المتفطرة السلية.

المعرفة:قائمة المقالات المميزة 2019
هذه قائمة المقالات المميزة التي نشرت في الصفحة الرئيسية بالمعرفة في عام 2018.
قائمة المقالات
| العنوان | المحتوى | تاريخ آخر رفع |
|---|---|---|
| گرافين | التطبيقات المذهلة للگرافين
الگرافين، هو مادة من ذرات كربون بسمك ذرة واحدة-ورقة مستوية sp2-bonded وهي مكتظة في شبكة بلورية تشبه مشط شمع العسل. ويمكن النظر إلى الگرافين على أنها سلك عشة الدجاج مصنوع من ذرات كربون بروابطها. الإسم يأتي من الگرافيت + -ene ; الگرافيت وهي نفسها تتكون من صحائف كثيرة من الگرافين مكدسة معاً. يمكن استخدام الگرافين لشفافيته في تصنيع الشاشات التي تعمل باللمس، لوحات الإنارة والخلايا الضوئية، كما يمكن الإفادة من هذه المادة في صناعة مجسات الغاز والإلكترونيات ذات المرونة العالية والقابلة للطي(كأجهزة المحمول والشاشات الإلكترونية)، مع إمكانية استعمالها في تصنيع بعض أجزاء الطائرات والأقمار الصناعية التي يتوجب أن تصنع من مواد تتمتع بخفة الوزن والتركيبة القوية. |
1 يناير 2019 |
| سوق على ضوء الشموع | سوق على ضوء الشموع
سوق على ضوء الشموع، هي لوحة للرسام الهولندي-البلجيكي پتروس فان شندل، المتخصص في رسم مظاهر الحياة اليومية، وكان يركز في لوحاته على رسم المناظر شبه المعتمة المضاءة بضوء الشموع، ولذلك، عرفت "بسيد الشموع". اللوحة رُسمت عام 1869، وهي زيت على خشب، بأبعاد 46 x 33 سم. |
1 يناير 2019 |
| متفطرة سلية | المتفطرة السلية
المتفطرة السلية (MTB)، هي عامل السل بكل أشكاله والذي يمكن أن يصيب الرئة والغدد اللمفاوية والعظام، والمفاصل والأغشية المصلية للرئة والصفن والسحايا والكلوتين والأمعاء والكظر والجلد. وقد تنتشر الجرثومة في الدم فيسبب السل الدخني. وهناك نوعان، السلي البشري والنوع البقري، كما أن هناك النوع الطيري والأنواع المجهولة التي تسبب أيضاً أعراضاً رئوية وجلدية. اكتشفه العالم الألماني روبرت كوخ عام 1882. |
1 يناير 2019 |
| النائب | تشيني.. أقوى نائب رئيس أمريكي
النائب، هو فيلم كوميدي-درامي أمريكي إنتاج عام 2018، كتبه وأخرجه آدم مكاي. الفيلم بطولة كريستيان بيل في دور ديك تشيني، وإمي آدمز، ستيڤ كارل، سام روكول، أليسون پيل، ليلي راب وتايلر پري. يدور الفيلم حول ديكي تشيلي ورغبته في أن يصبح أقوى نائب رئيس في التاريخ الأمريكي. وهو ثاني فيلم مسرحي يصور ادارة جورج دبليو بوش، بعد فيلم دبليو لأوليڤر ستون، وثالث تعاون بين بيل وآدمز، بعد فيلمي المقاتل والابتزاز الأمريكي. أُعلن عن الفيلم في نوفمبر 2016، من إخراج وتأليف مكاي. وقع بيل عقداً للقيام بدور تشيني في أبريل 2017، وانضم معظم فريق العمل على مدار بقية السنة. بدأ تصوير المشاهد الرئيسية في سبتمبر 2017. عُرض الفيلم في الولايات المتحدة في 25 ديسمبر 2018، بواسطة أناپورنا پيكتشرز. تسبب الفيلم في انقسام بين النقاد؛ حيث وصفه البعض "بالساخر الذكي" بينما انتقده آخرون بوصفه "عرض أخرق للكراهية السياسية"، مع توجيه كلاً من "الانتقادات اللاذعة والثناء الاحتفالي" لنص وإخراج مكاي. على الرغم من النقد المستقطب للفيلم نفسه، إلا أن الأداء وخاصة أداء بيل وآدمز، حاز ثناءاً عالمياً. ترشح الفيلم لنيل العديد من الجوائز، منها الستة الرائدة ضمن جوائز گولدن گلوب 76، جائزة أفضل فيل صور متحرك- موسيقي أو كوميدي. |
1 يناير 2019 |
| المجرة الحلزونية المضلعة | المجرة الحلزونية المضلعة
المجرة الحلزونية المضلعة هي مجرة حلزونية يتوسطها ضلع أو قضيب من النجوم. عثر على قضبان في ثلثي جميع المجرات الحلزونية تقريباً. ويؤثر الضلع الذي يتوسط المجرة كل من حركة النجوم والغاز الكوني في أذرع المجرة. ومن المجرات التي تصنف كمجرات ضلعية مجرة المرأة المسلسلة، واكتشفها وليام هرشل عام 1788 في كوكبة الوشق. إن مادة المجرات الضلعية تتركز بشكل أساسي في القرص المجرّي. حوالي %70 من المجرات المصنفة في الكون هي حلزونية، نصفها منتظمة ونصفها ضلعية. كتلة المركز لمثل هذه المجرات تقدر بـ100 مليار كتلة شمسية. |
1 يناير 2019 |
| حصار القدس | حصار القدس
حصار القدس كانت حملة عسكرية أطلقها نبوخذنصر الثاني، ملك بابل عام 597 ق.م. في 605 ق.م.، هزم نبوخذنصر الثاني، ملك بابل الفرعون نخاو في معركة قرقميش وتلى ذلك بغزو يهودا أثناء ملاحقته الجيش المصري. ولتفادي تدمير القدس، غيـَّر الملك يهويقيم المقدسي في سنة حكمه الثالث، ولاءه من مصر إلى بابل. ودفع الجزية من الخزينة في القدس، وبعض التحف من المعبد وبعض أعضاء الأسرة المالكة والنبلاء كرهائن. ومرة أخرى في 601 ق.م.، أثناء السنة الرابعة من حكمه، حاول نبوخذنصر دون جدوى أن يغزو مصر وتم صده بخسائر فادحة. أدى هذا الفشل إلى نشوب العديد من التمردات بين دويلات المشرق التي كانت تدين بالولاء لبابل، ومنهم يهودا، حيث توقف الملك يهويقيم عن دفع الجزية لنبوخذنصر واتخذ موقفاً ممالئاً لمصر. |
1 يناير 2018 |
| سمك المجداف | مرسال الملك التنين.. ينذر بتسونامي
سمك المجداف ويعرف أيضاً بملك الرنجة، هو سمك براقي ضخم وطويل للغاية يعيش في البحار المفتوحة ينتمي إلى فصيلة Regalecidae. رغم تواجده في جميع المحيطات المعتدلة إلى الإستوائية إلا أنه لم يشاهد إلا نادراً، تضم فصيلة سمك المجداف أربع أنواع في جنسين. أحدهما، سمك المجداف العملاق، وهو أطول سمكة عظمية حية، تنمو إلى أكثر من 11 متر. ولا يؤهلها ذلك لأن تـُعـّد أطول الأسماك، إذ أن بعض الأسماك الغضروفية مثل القرش المتشمس والقرش الحوت تتجاوزه في الطول. هذا النوع من الأسماك، الذي يتميز بالجسم الطويل الفضي والزعانف الحمراء، عادة ما يعيش في المياه العميقة ونادراً ما يطفو للسطح، بالرغم من وجود أسطورة تقول أنه حين يصعد سمك المجداف إلى سطح الماء فإن ذلك يكون نذيراً بقرب حدوث كارثة. حتى الاسم الياباني لهذا الصنف من الأسماك، ريوگو نو توكاي – والتي تعني “مرسال قصر الملك التنين” – وهو ما يشير إلى علاقة بالكوارث الطبيعية في الماضي. إلا أن سمعة سمك المجداف كنذير بدمار قريب ترسخت بعد أن جلبت الأمواج ما لا يقل عن عشر أسماك مجداف ميتة على السواحل الشمالية لليابان في 2010. وفي مارس 2011، وقع زلزال بقوة 9 على مقياس ريختر في شمال اليابان، مما تسبب في تسونامي عاتي، قتل نحو 19.000 شخص ودمّر مفاعل فوكوشيما النووي. ومع اقتراب الذكرى التاسعة لهذا الزلزال، فإن وسائل التواصل الاجتماعي اليابانية تموج بالقلق من معاودة ظهور سمك المجداف، بعد أن علـَقت سمكة مجداف ضخمة في شباك الصيد قرب ميناء إيميزو، في محافظة توياما الشمالية، باليابان، في يناير 2019. |
1 فبراير 2019 |
| دوامة قطبية | الدوامة القطبية
الدوامة القطبية، هي منطقة ضغط منخفض على ارتفاع عالي، تقع بالقرب من قطبي الأرض. يوجد دوامتين قطبيتين في الغلاف الجوي للأرض، فوق القطب الشمالي والجنوبي. كل دوامة قطبِية هي منطقة ضغط مستمرة واسعة النطاق، ذات ضهط منخفض تدور عكس عقارب الساعة عند القطب الشمالي (يُطلق عليها اسم الإعصار)، وفي اتجاه عقارب الساعة عند القطب الجنوبي، أي أن الدوامتين القطبيتين تدوران نحو الشرق حول القطبين. تقع قاعدت الدوامتين القطبيتين في التروپوسفير الأوسط والعلوي وتمتد حتى الستراتوسفير. تحت ذلك تقع كتلة كبيرة من الهواء البارد الكثيفة الباردة. في 30 يناير 2019، اجتاحت وسط وشمال الولايات المتحدة دوامة قطبية تاريخية وعاتية، حيث وصلت درجات الحرارة لأقل من 51 درجة تحت الصفر ووصلت الرياح لسرعات غير مسبوقة. |
1 فبراير 2019 |
| الأوزة الأم | الأوزة الأم
الأوزة الأم Mother Goose، هي الشخصية المؤلِفة لمجموعة من الحكايات الخرافية وأغاني الأطفال التي يتم نشرها غالبًا باسم أغاني الأوزة الأم (Mother Goose Rhymes). وظهرت كشخصية في واحدة من "أغاني الأطفال" (nursery rhyme). ويتم غالبًا أداء فن الحركات الإيحائية في عيد الميلاد (البانتوميم) المُسمى بالأوزة الأم في المملكة المتحدة. ولقد شكّلت الأغاني والقصص المسماة "الأوزة الأم" الأساس للعديد من عروض البانتوميم البريطانية الكلاسيكية. ويتم تصوير الأم الأوزة بصفةٍ عامة في الأدب وكتب الرسم التوضيحي كامرأة ريفية مسنة بقبعة طويلة وشال، وهو الزي المطابق للأزياء الريفية التي كان يتم ارتداؤها في ويلز في أوائل القرن العشرين، ولكنها توصف أحيانًا بـجوز (أوزة) (ترتدي عادةً قلنسوة). |
4 مارس 2019 |
| ضوء الليمون | ضوء الليمون
ضوء الليمون، هو نوع من الإضاءة قدمه العلماء في برج لندن عام 1830، في تجربة مع تصميمين آخرين للمصابيح. وحين اخترعه توماس درموند في 1816، كان ضوء الليمون يستخدم نفاثات من الأكسجين للمساعدة على تسخين الليمون الأخضر إلى الوهج/الاتقاد. وقد تم التوصل لضوء أكثر بهاء من اللهب لوحده. وكان ضوء الليمون قد أُستُخدم في الفنارات وعلى خشبات المسارح. إلا أنه بسبب احتياجه لرعاية متواصلة، فقد تم التخلي عنه لصالح الاختراعات الأحدث. |
4 مارس 2019 |
| سكة حديد بغداد | سكة حديد بغداد
سكة حديد بغداد، هو خط سكك حديدية تاريخي له أهمية دولية، وكان يربط أوروپا بآسيا الصغرى والشرق الأوسط. اكتملت آخر وصلاته عام 1940. ويربط محطة حيدر باشا، أمام أسطنبول، بالبصرة بالعراق، ويتصل عن طريق الخطوط البديلة والفرعية بشمال إيران وروسيا وسوريا وفلسطين. مولته خاصة رؤوس الأموال الألمانية، وانتهت وصلته المارة بالأناضول عام 1896، ثم ظهر مشروع أكبر لمده إلى بغداد، وتأسست شركة لهذا الغرض برؤوس أموال ألمانية، ولم تلبث أن احتجت لدى تركيا كل من فرنسا وروسيا، وإنگلترة على الخصوص، التي رأت في الخط المقترح تهديداً مباشراً لإمبراطوريتها في الهند، فتوقف العمل عدة سنوات بسبب هذه الاعتراضات والعقبات الهندسية، ولكن استؤنف العمل عام 1911، وأثر ذلك في المنافسات الاستعمارية. وفي نهاية الحرب العالمية الأولى لم يبق لإتمامه إلا الجزء الممتد من الموصل إلى سامراء، فبني برؤوس الأموال الإنگليزية خاصة. إذ أصبح لإنگلترة إذ ذاك السيطرة على العراق، وقد صار مملكة مستقلة تحت الانتداب البريطاني أول الأمر. |
4 مارس 2019 |
| عملية عوڤدا | عملية عوڤدا
عملية عوڤدا، هي عملية عسكرية قامت بها قوات الدفاع الإسرائيلي خلال حرب 1948، من 5 مارس - 10 مارس 1949، تحت قيادة اسحق رابين، للاستيلاء على منطقة أم الرشراش (إيلات) في عام 1948. ونتج عنها إحتلال منطقة صحراء النقب، وأم الرشراش في مارس 1949. وإيلات من منظور عربى تاريخى هي أم الرشراش منطقة مصرية علي الحدود الفلسطينية المصرية، وذلك وفقا للفرمان العثماني الصادر عام 1906م الذي يرسم هذه الحدود دوليا، وإذا ما نظرنا إلي خرائط السلام – سواء المصرية أو الاسرائيلية – فلن نجد ذكرا لمكان بهذا الاسم، ويرى بعض المتخصصين في قضايا الحدود أن أم الرشراش التي تحولت إلي إيلات بعد إتفاقية كامب ديفيد. ولكن أسباب وتداعيات استيلاء الإسرائيليون علي منطقة أم الرشراش المصرية تفوق ذلك بكثير، وهي جزء هام من استراتيجية الصهاينة الشاملة العسكرية والسياسية والاقتصادية. |
4 مارس 2019 |
| الكرمس الفلمنكي | الكرمس الفلمنكي لروبنز
الكرمس الفلمنكي، هي احدى لوحات الرسام البلجيكي پيتر پول روبنز وتصور مهرجان الكرمس الذي يحتفل به في هولندا والأجزاء الشمالية من فرنسا. هذه اللوحة الذي يصل عرضها إلى 261 سم، وارتفاعها إلى 149 سم، كان الملك الفرنسي لويس الرابع عشر اشتراها عند نهاية حياته، ولذلك توجد اليوم في متحف اللوڤر الباريسي وتعتبر من أهم مقتنياته، إضافة الى أنها تعتبر من أوائل اللوحات الفلامندية التي دخلت مجموعات اللوحات الملكية الفرنسية. |
4 مارس 2019 |
| ڤينوس ومارس | ڤينوس ومارس
ڤينوس ومارس هي لوحة رسمها الرسام الإيطالي ساندرو بوتيتشلي حوالي عام 1485. تصور اللوحة الإلهة الرومانية ڤينوس، إلهة الحب، ومارس، إله الحرب، في مشهد رمزي يعبر عن الجمال والشجاعة. يتأرجح الزوجان الممتلئان بالشباب والشهوة في مشهد طبيعي، محاطان ساتير رضيع نابض بالحركة. وهي الوحيدة من بين هذه اللوحات التي لا تعرض في أوفيزي بفلورنسا، وتُعرض في المتحف الوطني بلندن منذ عام 1874. |
1 أبريل 2019 |
| مسجد الحاكم بأمر الله | مسجد الحاكم بأمر الله
مسجد الحاكم بأمر الله، هو مسجد بُني عام 380 هـ في عهد العزيز بالله الفاطمي، الذي بدأ في سنة 379هـ ( 989م) في بناء مسجد آخر خارج باب الفتوح ولكنه توفى قبل اتمامه فأتمه ابنه الحاكم بأمر الله 403هـ ( 1012-1013م) لذا نسب اليه وصار يعرف بجامع الحاكم. يبلغ طول المسجد 12.005 متر وعرضه 113 متر فمساحته أقل من مساحة جامع عمرو بن العاص. أهمل المسجد لفترات طويلة حتى تحولت أروقته إلى مخازن لتجار الآخرين المحيطين بالمنطقة، إذ أنها منطقة تجارية، حتى عصر الرئيس أنور السادات والذي طلبت طائفة الشيعة البهرة الذي بدؤوا في الهجرة إلى مصر، الإذن بتجديده بالجهود الذاتية - ذلك أنه مكان مقدس بالنسبة لهم كما أن الحاكم بأمر الله نفسه شخصية مقدسة وتم ذلك، ودعي السادات إلى افتتاح المسجد وكان هناك تخوف من أن يكون ذلك محاولة لأغتياله، إلا أنه لم يحدث شيء، ومنذ ذلك الحين يقوم الشيعة البهرة الذين هاجروا إلى مصر واستقروا بها كتجار وخصوصاً في منطقة القاهرة العتيقة والجمالية وما حولها برعاية الجامع وهو مفتوح لجميع الطوائف بالصلاة بها. |
1 أبريل 2019 |
| معركة المنصورة | المنصورة.. نهاية الحملة الصليبية السابعة
معركة المنصورة، معركة دارت رحاها في مصر من 8 إلى 11 فبراير 1250 بين القوات الصليبية (الفرنج) بقيادة لويس التاسع (Louis IX) ملك فرنسا (القديس لويس فيما بعد)، والقوات الأيوبية بقيادة الأمير فخر الدين يوسف بن شيخ الشيوخ وفارس الدين أقطاي الجمدار وركن الدين بيبرس البندقداري. وانتهت المعركة بانتصار الأيوبيين، وسُمح للويس التاسع بمغادرة مصر مقابل تسليم دمياط للمصريين، والتعهد بعدم العودة إلى مصر مرة أخرى، بالإضافة إلى دفعه فدية قدرها 400 ألف دينار تعويضاً عن الأضرار التي ألحقها بمصر. |
1 أبريل 2019 |
| الانتداب البريطاني على فلسطين | الانتداب البريطاني على فلسطين
الانتداب البريطاني على فلسطين هي سلطة حكمت فلسطين لمدة 28 عام بين يوليو 1920 ومايو 1948، وبالحدود التي قررتها بريطانيا وفرنسا بعد تفكيك الامبراطورية العثمانية إثر الحرب العالمية الأولى وبموجب معاهدة سيڤر. في 11 سبتمبر 1922 أقرت عصبة الأمم الانتداب بشكل رسمي على أساس وعد بلفور. غطت منطقة الانتداب ما يعرف اليوم فلسطين التاريخية (أي المنطقة التي تقع فيها اليوم كل من دولة إسرائيل والأراضي الفلسطينية - الضفة الغربية وقطاع غزة) بالإضافة إلى منطقة شرق الأردن (اليوم: المملكة الأردنية الهاشمية) غير أن منطقة شرق الأردن تمتعت بحكم ذاتي (فيما كان يعرف بامارة شرق الاردن) ولم تخضع لمبادئ الانتداب أو لوعد بلفور. كانت مدينة القدس عاصمة الانتداب حيث سكن الحاكم البريطاني ومؤسسات حكومة الانتداب. عند بداية فترة الانتداب أعلنت بريطانيا هدفاً له وهو تحقيق وعد بلفور، أي فتح الباب أمام اليهود الراغبين في الهجرة إلى فلسطين وإقامة "وطن قومي" يهودي فيها. أما في منتصف ثلاثينات القرن العشرين فغيرت بريطانيا سياستها وحاولت وقف توافد اليهود على فلسطين ومنع شراء الأراضي من قبل اليهود. |
1 أبريل 2019 |
| هاكا | الهاكا.. رقصة التحدي
الهاكا هي رقصة طقسية أو تحدي تقليدي في ثقافة الماوري. وهي رقصة بوضعية جسدية معينة تؤديها مجموعة، مع القيام بحركات قوية والضرب بالقدمين، يرافقه موسيقى إيقاعية صاخبة. على الرغم من أنها عادة ما ترتبط بالتحضيرات التقليدية للمحاربين الذكور، إلا أن الهاكا كانت تؤدى من قبل الرجال والنساء منذ فترة طويلة، وفي ثقافة الماوري هناك العديد من أنواع من الرقص التي تؤدى لأغراض اجتماعية. تؤدى الهاكا ترحيباً بكبار الضيوف، أو للاعتراف بالإنجازات العظيمة، في المناسبات أو الجنازات. |
1 أبريل 2019 |
| الأستروكس | ماذا تعرف عن الأستروكس؟
الأستروكس، هو دواء نفسي يستخدم بصفة رئيسية كعقار ترفيهي. وتشمل التأثيرات المرغوبة الأحاسيس المتغيرة والطاقة المتزايدة، التقمص الوجداني، والمتعة. عند تناوله عن طريق الفم، تبدأ التأثيرات بعد 30-45 دقيقة وتستمر إلى 3-6 ساعات. من 2018، لم يوافق على استخدام هذه المادة طبياً. وتشمل الآثار الضارة الإدمان، مشكلات في الذاكرة، جنون الإرتياب، صعوبة النوم، صرير الأسنان، زغللة العين، التعرق، وسرعة ضربات القلب. تم الإبلاغ عن حالات وفاة بسبب زيادة درجة حرارة الجسم والجفاف. بعد الاستخدام عادة ما يشعر الشخص بالاكتئاب والإرهاق. يعمل العقار بصفة رئيسية على زيادة نشاط الناقلات العصبية؛ السروتونين، الدوپامين، ونورأدرينالين في مناطق الدماغ. ينتمي إلى مجموعة الأدوية الأمفيتامينية المستبدلة وله تأثيرات منبهة ومهولسة. |
1 أبريل 2019 |
| استقلال الجزائر | استقلال الجزائر
الثورة الجزائرية أو ثورة المليون شهيد، اندلعت في 1 نوفمبر 1954 ضد المستعمر الفرنسي ودامت 7 سنوات ونصف. استشهد فيها أكثر من مليون ونصف مليون جزائري. وقامت الثورة بقيادة جبهة التحرير الوطني الجزائرية ونجحت الثورة في تحقيق أهم أهدافها بحصول الجزائر على إستقلاله في 5 يوليو 1962. أعلن استقلال الجزائر في 5 يوليو 1962، وفي الحقيقة كانت فرنسا أعلنت هذا الاستقلال على لسان الجنرال ديگول قبل ذلك بقليل، وتحديداً في الثالث من يوليو. غير أن الخامس من يوليو سجل حلول العام الـ132 لاحتلال الجزائر من قبل الفرنسيين. ولذا تقرر الإحتفال بالإستقلال في هذا اليوم بالذات. ولكي تحرز الجزائر استقلالها تعين عليها ان تخوض الكفاح المسلح على مدى 8 سنوات قتل خلالها حسب مختلف المصادر ما بين 500 ألف جزائري إلى مليون ونصف المليون. |
2 يوليو 2019 |
| ثورة العشرين | الثورة العراقية الكبرى
ثورة العشرين، أو الثورة العراقية ضد البريطانيين، أو الثورة العراقية الكبرى، بدأت في بغداد في صيف 1920 بمظاهرات شعبية خرج فيها العراقيون، وشملت احتجاجات الضباط الساخطين من الجيش العثماني القديم، ضد الاحتلال البريطاني للعراق. حازت الثورة زخماً عندما امتدت إلى المناطق ذات الأغلبية الشيعية في الفرات الأوسط والأدنى. كان الشيخ مهدي الخليصي من أشهر القادة الشيعة للثورة. تعاون السنة والشيعة أثناء الثورة وكذلك التجمعات القبلية، سكان الحضر، والكثير من الضباط العراقيين في سوريا. كانت أهداف الثورة هي الاستقلال عن الحكم البريطاني وتأسيس حكومة عربية. على الرغم من أن الثورة قد حققت بعض النجاح الأولي، في نهاية أكتوبر 1920، تمكن البريطانيون من قمع الثورة. بالرغم من أن الثورة انتهت إلى حد كبير في نهاية 1920، إلى إنها استمرت جزئياً حتى عام 1922. أثناء ثورة العشرين، اندلع تمرد آخر ضد البريطانيين في شمال العراق قام به الأكراد، الذين حاولوا الحصول على الاستقلال. كان الشيخ محمد البرزنجي من أبرز قادة الثورة الكردية. |
2 يوليو 2019 |
| لويس التاسع | لويس التاسع أسيراً في المنصورة
لويس التاسع، (1214-1270)، هو ملك فرنسا من 1226 حتى 1270، قاد الحملة الصليبية السابعة عام 1245 التي انتهت بانتصار المسلمين وأسر لويس التاسع في المنصورة. حين وصل لويس التاسع دمياط كان الملك الصالح نجم الدين أيوب بدمشق، فلما علم بأخبارها عاد مسرعاً إلى مصر، وتحركت الحملة بعد نزولها إلي جيزة دمياط باتجاه فارسكور إلا أن الملك الصالح نجم الدين أيوب وافته المنية فأخفت زوجته شجرة الدر خبر وفاته لحين عودة ابنه توران شاه من حصن كيفا الواقع على ضفاف دجلة. تولي المملوك بيبرس البندقداري قيادة قوات المسلمين وإنزال الهزيمة بالفرنج في معركة المنصورة التي أبلي العامة فيها بلاء حسنا وقتل في هذه المعركة روبرت كونت أرتوا أخو الملك لويس التاسع والذي كان علي رأس الجيش بينما كان لويس التاسع عند مخاضة سلمون علي بحر أشموم طناح في طريقه إلى المنصورة. وصل الملك توران شاه وتسلم قيادة الجيش المصري، وبدأ أعماله الحربية بالاستيلاء على جميع المراكب الفرنسية التي تحمل المؤن للمعتدين، وبذلك عرقل خطوط إمدادهم، فاضطرهم إلى التقهقر بعد أن نفدت ذخيرتهم وعتادهم الحربي فقرر لويس التاسع الرجوع إلي دمياط والتحصن بها ولكن قوات المسلمين قطعت الطريق عليهم وطاردوهم وأخذ يغير على الجيش الصليبي أثناء انسحابه تجاه دمياط، ثم طوقهم وسد عليهم طريق الانسحاب وانقضت عليهم قوات المسلمبن قرب بلدة ميت الخولى عبد الله بالقرب من المنصورة وتم أسر لويس التاسع ملك فرنسا ونقله إلى دار كاتب الإنشاء فخر الدين بن لقمان. بلغ قتلى الصليبين في هذه المعركة - كما يذكر المؤرخون - ثلاثين ألفا، فعرض التسليم وطلب الأمان لنفسه ولمن بقى معه من خاصة عساكره وحاشيته، فأجابه إلى الأمان الذي طلب. استسلم لويس الحزين لمصيره حيث أرسل أسيراً إلى دار إبراهيم بن لقمان قاضى المنصورة، واشترط المصريون تسليم دمياط، وجلاء الحملة عن مصر قبل إطلاق سراح الملك الأسير و غيره من كبار الأسرى، كما اشترطوا دفع فدية كبيرة للملك ولكبار ضباطه، ولم يكن أمام لويس إلا الإذعان فافتدى نفسه وبقية جنده بفدية كبيرة قدرت بعشرة ملايين من الفرنكات. |
2 يوليو 2019 |
| بائع السحلب | بائع السحلب
بائع السحلب، هي لوحة رسمها المستشرق النمساوي لودڤيگ دويتش عام 1886، وتصور اللوحة بائع يقوم ببيع وتوزيع السحلب في أحد أحياء القاهرة. ذهب لودڤيگ إلى مدينة القاهرة وكان يرسم اللوحات على الورق، ومن ثم يقوم برسمها لاحقاً في محترفه في باريس بأسلوب واقعي دقيق. كثير من النقاد أجزموا بأنه كان يعتمد ولو جزئياً على الصور الفوتوغرافية، إذ أن هذا الالتزام برسم أصغر التفاصيل بدقة شديدة لم يكن مألوفاً عند معاصريه. |
2 يوليو 2019 |
| سقوط قرطبة | سقوط قرطبة
سقوط قرطبة وقع عام 1236 أثناء حرب الاسترداد قامت به قوات فرديناند الثالث، ملك قشتالة وليون، ويعتبر بمثابة نهاية الحكم الإسلامي للمدينة والذي بدأ عام 711. أواخر 1236 خرج جماعة من فرسان قشتالة المغامرين صوب قرطبة، واحتموا بظلام الليل وخيانة البعض ونجحوا في الاستيلاء على منطقة من مناطق المدينة تعرف بالربض الشرقي، وكانت قليلة السكان، ضعيفة الحراسة، وقتلوا كثيرًا من سكانها، وفر الباقون إلى داخل المدينة، وبعدما زالت المفاجأة جاءت حامية المدينة وهاجموا هؤلاء الغزاة الذين تحصنوا بالأبراج، وبعثوا في طلب النجدة والإمداد، فجاءتهم نجدة صغيرة من إخوانهم النصارى، وتحرك فرناندو على الفور صوب قرطبة، غير ملتزم بالمعاهدة التي عقدها مع ابن هود الذي تتبعه المدينة، وبدأت تتجمع قوات من النصارى تحت أسوار المدينة ويزداد عددها يومًا بعد يوم، وتتوقد قلوبهم حماسة وحمية، وبدأ الملك يضع خطته للاستيلاء على المدينة العظيمة. تطلع القرطبيون في هذه اللحظات الحرجة إلى ابن هود لإنجادهم والدفاع عن مدينتهم باعتباره حاكم المدينة الشرعي، فاستجاب لهم حين علم بالخطر الداهم الذي يحيط بالمدينة العريقة، وخرج في جيش كبير من بلنسية إلى قرطبة، وعسكر على مقربة منهم، وكان أهل قرطبة ينتظرون مقدمه واشتباكه مع المسيحيين في موقعة فاصلة، وبدلاً من أن يفعل ذلك ظل واقفًا في مكانه لا يحرك ساكنًا، ولا يتحرش بهم، ولو أنه اشتبك معهم لحقق نصرًا هائلاً وألحق بهم هزيمة كبيرة، فحشودهم لم تكن ذات شأن، جمعتها الحماسة والحمية، وفرسانهم لم يكن يتجاوزا المائتين. ويختلف المؤرخون في السبب الذي جعل ابن هود يقف هذا الموقف المخزي، وهو الذي ملأ الأندلس كلامًا بأنه سيعمل على تحرير الأندلس من العدوان المسيحي، وعلى إحياء الشريعة وسننها. يذهب بعض المؤرخين إلى أن قسوة الجو وهطول الأمطار بشدة ونقصان المؤن هو الذي حمل ابن هود على اتخاذ هذا الموقف. |
2 يوليو 2019 |
| سعفة جلدية | ما هي السعفة الجلدية؟
السعفة الجلدية أو التينيا، هي عدوى جلدية تتميز بوجود بقع حمراء أو مائلة للبني على الجلد حيث تكون أقل تلوناً في المركز مما يعطي شكل الخاتم. يمكن لهذه البقع أن تتواجد في أي مكان في الجسم حيث تأخذ مسميات عديدة بناءً على مكان الإصابة. ففي الأقدام تدعى الإصابة بمرض قدم الرياضي، وتدعى حكة جوك عندما تصيب المنطقة العجانية عند تتواجد على الجسم، وغالباً ما يشار إليها بالقوباء الحلقية كما وتدعى سعفة الرأس عندما تصيب فروة الرأس. يسبب هذا المرض فطريات طفيلية تنتمي لمجموعة الفطور الجلدية. تتغذى هذه الفطريات على الكيراتين ولذلك فهي تتواجد على الطبقة الخارجية للجلد والأظافر بشكل طفيلي. أكثر الأماكن المحببة لهذه الفطريات هي الأماكن الرطبة والدافئة والمحمية من أشعة الشمس. |
2 يوليو 2019 |